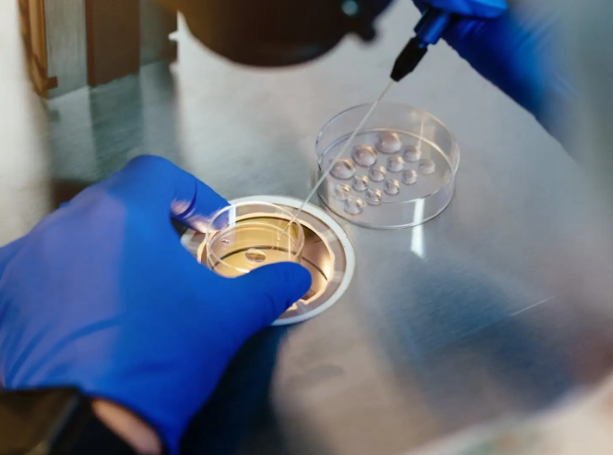

目前金华尚未公布2026年三代试管收费标准,具体费用因医院、个人情况而异。以金华市中心医院为例,大致费用包括术前检查费、促排卵药物费、取卵手术费、胚胎培养费、PGT-A筛查费、移植手术费、黄体支持费等,总费用可能在4-8万元不等,甚至更高。这只是一个大概范围,具体费用需要根据实际情况而定。
想要顺利做三代试管婴儿技术,了解具体的费用构成至关重要。这不仅关系到家庭的经济预算,更能帮助您提前做好准备,避免在治疗过程中因费用问题而产生不必要的压力。接下来,我们将详细解读金华地区三代试管婴儿的各项费用,帮助您对整个治疗过程有一个清晰的了解。
金华地区三代试管婴儿技术费用,并非一个固定数值,而是由多个项目费用累加而成。这些费用项目主要可以分为以下几类:
一、术前检查费用:在正式进入试管婴儿周期之前,夫妻双方都需要进行一系列的全面检查,以评估身体状况是否适合做试管婴儿治疗,并排除一些可能影响治疗效果的因素。这些检查项目包括:男方精液常规分析、染色体检查;女方妇科检查、性激素六项、输卵管造影、宫腔镜检查、染色体检查等。检查费用因项目和医院而异,通常在几千元到一万元不等。
二、促排卵药物费用:这是三代试管婴儿过程中一项比较重要的费用,也是费用波动较大的部分。促排卵药物的作用是刺激卵巢,使卵巢排出多个成熟卵子,以提高妊娠成功率。促排卵药物种类繁多,价格差异较大,进口药价格通常高于国产药。具体用药方案和用药量,需要根据患者的个体情况而定,因此费用也存在较大差异,通常在1万元到3万元不等,甚至更高。
三、取卵手术费用:取卵手术是将成熟的卵子从卵巢中取出,是一个相对简单的微创手术。费用相对固定,通常在几千元左右。
四、胚胎培养费用:取出的卵子需要在实验室进行体外受精和培养,直到胚胎发育到合适的阶段。胚胎培养费用包括培养基、设备等,费用相对固定,通常在几千元左右。
五、PGT-A筛查费用:这是三代试管婴儿技术区别于一代、二代试管婴儿技术的主要费用项目。PGT-A筛查是通过对胚胎进行染色体检查,筛选出染色体正常的胚胎进行移植,以降低染色体异常导致的流产或出生缺陷风险。PGT-A筛查费用相对较高,通常在每枚胚胎几千元不等,具体费用取决于筛查的胚胎数量。
六、胚胎移植费用:将筛选出的健康胚胎移植到子宫腔内,这个过程相对简单,费用通常在几千元左右。
七、黄体支持费用:胚胎移植后,需要进行黄体支持治疗,以维持子宫内膜的稳定,提高着床率。黄体支持治疗通常需要使用药物,费用在几千元到一万元不等。
八、其他费用:除了以上主要费用外,还可能有一些其他的费用,例如:手术室费、麻醉费、住院费等。这些费用相对较少,通常在几千元以内。
*图文内容仅供学习参考,不能作为诊断依据,个体有差异,如有不适请前往正规医院就诊!

上海
重庆
北京
天津